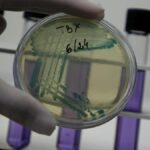
health-matters-newsletter-surveilling-infections

Soosan Jacob, Director and Chief of Dr. Agarwals Refractive and Cornea Foundation, has been appointed as the President of the International Society of Refractive Surgery (ISRS). ISRS is a global professional organisation dedicated to advancing the art, science and ethical practice of refractive, cornea, cataract and lens‑based surgery for improved vision.
Dr. Soosan Jacob is the second Indian to be elected as President of ISRS, after ophthalmologist Amar Agarwal. She is also the Associate Editor at the Journal of Refractive Surgery, a monthly international peer-reviewed forum for original research, review, and evaluation of refractive, cataract, and lens-based surgical procedures, according to a press release.
Published – January 21, 2026 05:30 am IST